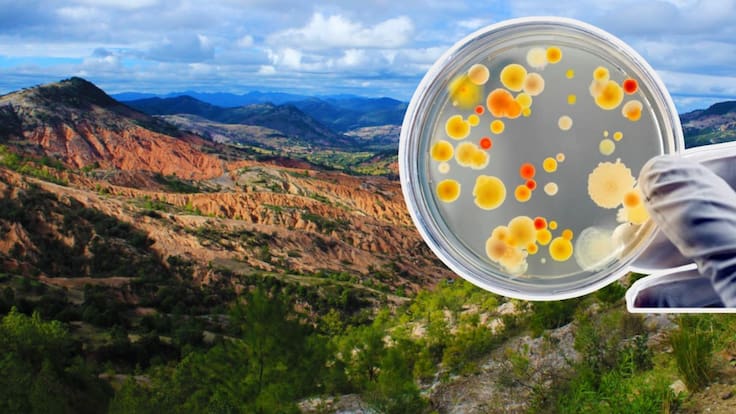
Descubren en Oaxaca un “ejército de bacterias” que podrían transformar la agricultura

Nacional.

Dictan prisión preventiva oficiosa contra suegro y cuñado de Iván Archivaldo Guzmán
Un juez federal dictó la medida de prisión preventiva oficiosa contra dos familiares de Chapito detenidos en Zapopan, Jalisco.
Esta es la tienda de lujo donde fue captado José Ramón López Beltrán, hijo de AMLO
En redes sociales resurgieron las críticas por el discurso de austeridad de la Cuarta Transformación
Más Noticias
Página735



